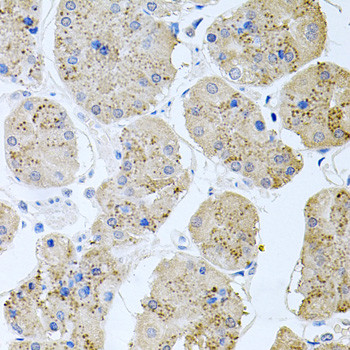
RAPSN Antibody in Immunohistochemistry (Paraffin) (IHC (P))

Search
Invitrogen
RAPSN Polyclonal Antibody
{{$productOrderCtrl.translations['antibody.pdp.commerceCard.promotion.promotions']}}
{{$productOrderCtrl.translations['antibody.pdp.commerceCard.promotion.viewpromo']}}
{{$productOrderCtrl.translations['antibody.pdp.commerceCard.promotion.promocode']}}: {{promo.promoCode}} {{promo.promoTitle}} {{promo.promoDescription}}. {{$productOrderCtrl.translations['antibody.pdp.commerceCard.promotion.learnmore']}}
图: 1 / 3
RAPSN Antibody (PA5-93169) in IHC (P)



产品信息
PA5-93169
种属反应
宿主/亚型
分类
类型
抗原
偶联物
形式
浓度
规格
纯化类型
保存液
内含物
保存条件
运输条件
RRID
产品详细信息
Positive Samples: B-cell, Mouse skeletal muscle, Mouse brain, Rat skeletal muscle, Rat brain; Cellular Location: Cell junction, Cell membrane, Cytoplasm, Cytoplasmic side, Peripheral membrane protein, cytoskeleton, postsynaptic cell membrane, synapse
靶标信息
This gene encodes a member of a family of proteins that are receptor associated proteins of the synapse. The encoded protein contains a conserved cAMP-dependent protein kinase phosphorylation site, and plays a critical role in clustering and anchoring nicotinic acetylcholine receptors at synaptic sites by linking the receptors to the underlying postsynaptic cytoskeleton, possibly by direct association with actin or spectrin. Mutations in this gene may play a role in postsynaptic congenital myasthenic syndromes. Alternatively spliced transcript variants encoding multiple isoforms have been observed for this gene.
仅用于科研。不用于诊断过程。未经明确授权不得转售。
篇参考文献 (0)
生物信息学
蛋白别名: 43 kDa postsynaptic protein; 43 kDa receptor-associated protein of the synapse; 43kDa acetylcholine receptor-associated protein; Acetylcholine receptor-associated 43 kDa protein; CMS1D; CMS1E; MGC3597; RAPsyn; receptor-associated protein of the synapse, 43 kDa; RING finger protein 205
基因别名: 43kDa; CMS11; CMS4C; FADS; FADS2; Nraps; Raps; RAPSN; RAPSYN; RNF205
UniProt ID: (Human) Q13702, (Mouse) P12672
Entrez Gene ID: (Human) 5913, (Rat) 362161, (Mouse) 19400